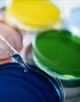

Werkzeug und Vorlagen zum Glasritzen
Sie sind auf der Suche nach kreativen Ideen die Sie schnell umsetzen können?
Sie suchen neue Basteltechniken die leicht anzuwenden sind?
Sie hantieren gerne mit Deko und Bastelartikeln herum?
Dann sind Sie hier genau richtig!!!
HERZLICH WILLKOMMEN
auf unserer Website speziell zum Thema Dekorieren und Graphieren von Glas mit Glasritzer
Sie finden Werkzeug, Vorlagen und Tips rund um das Schleifen von Glas. Sie finden Schleifwerkzeug sowie passende Schleifer zum Einsetzen in die entsprechenden Einsätze. Elektroschleifer oder Halter zum Glasritzen von Hand.
Falls Ihnen ein Produkt zusagt, können Sie das gerne online bestellen. Sie werden an den Shop weitergeleitet. Der Verkauf der Produkte erfolgt über www.basteltreff.ch
Falls Sie Fragen, Anregungen oder Wünsche haben rufen Sie uns über uns an:
Tel: +41 62 724 03 04
em ail: btinfo [at] basteltreff [Punkt] ch
Auf den folgenden Seiten finden Sie alles was Ihre Kreativität benötigt um zum zum Glasritzen angeregt zu werden und um künstlerisch umgesetzt zu werden.
Ich wünsche Ihnen viel Spass und freue mich auf Ihre Kontaktaufnahme Direkt auf die Produkteseite der Glasritzer gelangen Sie hier
Ihre
Manuela Obrist
Weitere Informationen zur Firma und zum Basteltreff.ch erfahren Sie im Impressum
Unser Sortiment:
Letztes Update am Dienstag, 15. März 2011 um 14:21:19 Uhr.